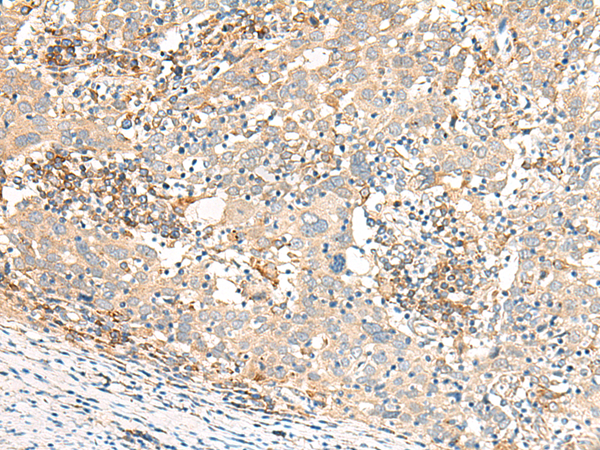
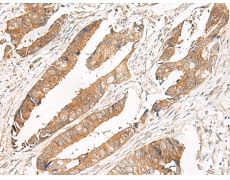
一抗

中文名稱: 兔抗GBP4多克隆抗體
|
Background: |
Guanylate-binding proteins, such as GBP4, are induced by interferon and hydrolyze GTP to both GDP and GMP (Vestal, 2005 [PubMed 16108726]). Plays a role in erythroid differentiation. |
|
Applications: |
ELISA, IHC |
|
Name of antibody: |
GBP4 |
|
Immunogen: |
Synthetic peptide of human GBP4 |
|
Full name: |
guanylate binding protein 4 |
|
Synonyms: |
Mpa2 |
|
SwissProt: |
Q96PP9 |
|
ELISA Recommended dilution: |
5000-10000 |
|
IHC positive control: |
Human cervical cancer and Human colorectal cancer |
|
IHC Recommend dilution: |
30-150 |

購物車
購物車 幫助
幫助
 021-54845833/15800441009
021-54845833/15800441009